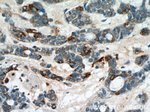
RABL3 Antibody in Immunohistochemistry (Paraffin) (IHC (P))
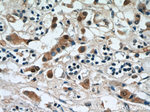
RABL3 Antibody in Immunohistochemistry (Paraffin) (IHC (P))
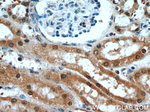
RABL3 Antibody in Immunohistochemistry (Paraffin) (IHC (P))

Search
Proteintech
RABL3 Polyclonal Antibody
{{$productOrderCtrl.translations['antibody.pdp.commerceCard.promotion.promotions']}}
{{$productOrderCtrl.translations['antibody.pdp.commerceCard.promotion.viewpromo']}}
{{$productOrderCtrl.translations['antibody.pdp.commerceCard.promotion.promocode']}}: {{promo.promoCode}} {{promo.promoTitle}} {{promo.promoDescription}}. {{$productOrderCtrl.translations['antibody.pdp.commerceCard.promotion.learnmore']}}
产品信息
11916-1-AP
种属反应
已发表种属
宿主/亚型
分类
类型
抗原
偶联物
形式
浓度
规格
纯化类型
保存液
内含物
保存条件
运输条件
产品详细信息
Immunogen sequence: MASLDRVKV LVLGDSGVGK SSLVHLLCQN QVLGNPSWTV GCSVDVRVHD YKEGTPEEKT CYIELWDVGG SVGSASSVKS TRAVFYNSVN GIIFVHDLTN KKSSQNLRRW SLEALNRDLV PTGVLVTNGD YDQEQFADNQ IPLLVIGTKL DQIHETKRHE VLTTTAFLAE DFNPEEINLD CTNPRYLAAG SSNAVKLSRF FDKVIEKRYF LREGNQIPGF PDRKRFGAGT LKSLHYD (1-236 aa encoded by BC020832)
靶标信息
Predicted to enable GTP binding activity; GTPase activity; and protein homodimerization activity. Involved in regulation of Ras protein signal transduction and regulation of protein lipidation. Predicted to be active in endomembrane system. Implicated in pancreatic cancer.
仅用于科研。不用于诊断过程。未经明确授权不得转售。
生物信息学
蛋白别名: RAB, member of RAS oncogene family-like 3; Rab-like protein 3; unnamed protein product
基因别名: 4930553C05Rik; AA958834; PNCA5; RABL3
UniProt ID: (Human) Q5HYI8, (Mouse) Q9D4V7
Entrez Gene ID: (Human) 285282, (Mouse) 67657